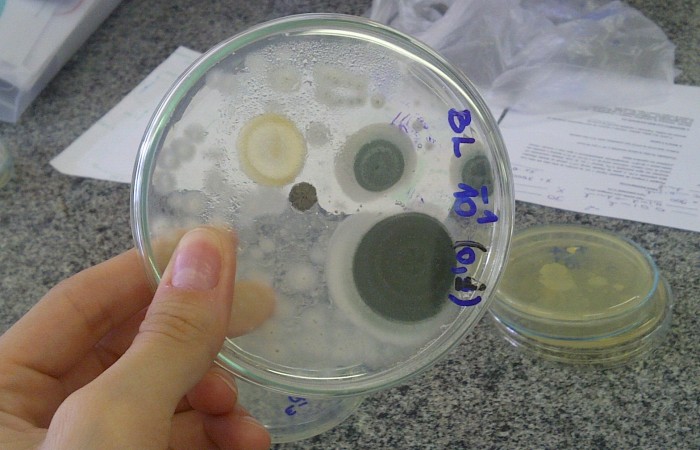

O termo acessibilidade significa incluir a pessoa com deficiência na participação de atividades como o uso de produtos, serviços e informações.
Alguns exemplos são os prédios com rampas de acesso para cadeira de rodas e banheiros adaptados para deficientes.
Se você está procurando a
Comissão de Acessibilidade da UFSM, clique aqui.
Na internet, acessibilidade refere-se principalmente às recomendações do WCAG (World Content Accessibility Guide) do W3C e no caso do Governo Brasileiro ao e-MAG
(Modelo de Acessibilidade em Governo Eletrônico).
O e-MAG está alinhado as recomendações internacionais, mas estabelece padrões de comportamento acessível para sites governamentais.
Na parte superior do site da UFSM existe uma barra de acessibilidade onde se encontra atalhos de navegação padronizados e a opção para alterar o contraste.
Essas ferramentas estão disponíveis em todas as páginas do portal.
Os padrões de atalhos do governo federal são:
Teclando-se Alt + 1 em qualquer página do portal, chega-se diretamente ao começo do conteúdo principal da página.
Teclando-se Alt + 2 em qualquer página do portal, chega-se diretamente ao início do menu principal.
Teclando-se Alt + 3 em qualquer página do portal, chega-se diretamente em sua busca interna.
No caso do Firefox, em vez de Alt + número, tecle simultaneamente Alt + Shift + número.
Sendo Firefox no Mac OS, em vez de Alt + Shift + número, tecle simultaneamente Ctrl + Alt + número.
No Opera, as teclas são Shift + Escape + número. Ao teclar apenas Shift + Escape, o usuário encontrará uma janela com todas as alternativas de ACCESSKEY da página.
Ao final desse texto, você poderá baixar alguns arquivos que explicam melhor o termo acessibilidade e como deve ser implementado nos sites da Internet.
Leis e decretos sobre acessibilidade: